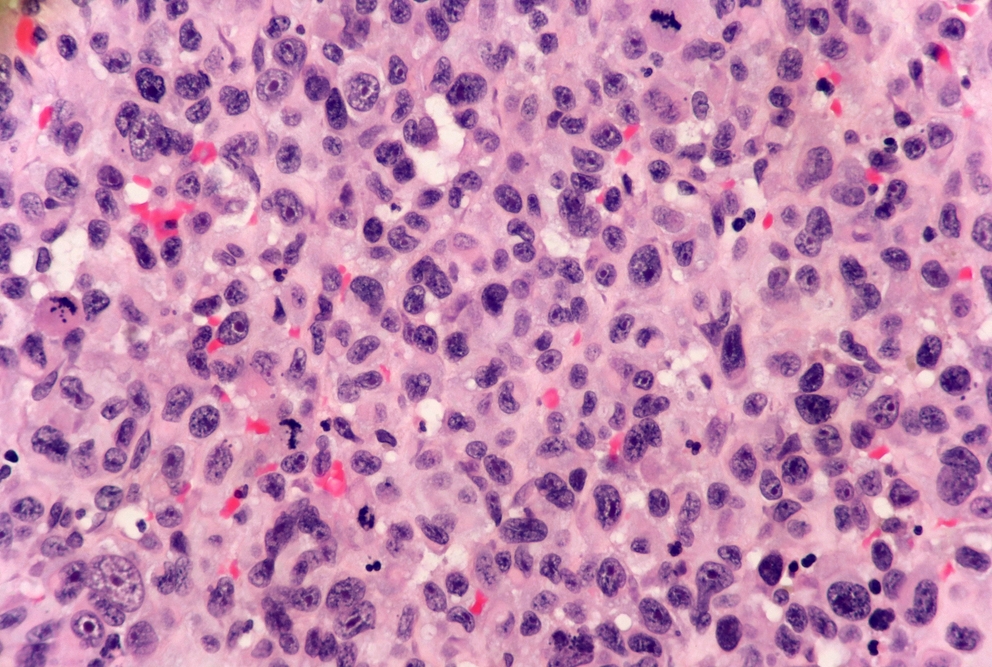

Before a cell commits fully to the process of dividing itself into two new cells, it may ensure the appropriateness of its commitment by staying for many hours—sometimes more than a day—in a reversible intermediate state, according to a discovery by researchers at Weill Cornell Medicine. Their revelation of this fundamental feature of biology includes details of its mechanisms and dynamics, which may inform the development of future therapies targeting cancers and other diseases.
In their study, published June 26 in Nature, the researchers developed new tools allowing them to track over time the activation state of E2F, a transcription factor protein long known as the master switch for initiating division in mammalian cells. They found unexpectedly that E2F, before being fully activated, can remain in a potentially lengthy state of partial and reversible activation that may end in full commitment to cell division or a reversion to the usual, non-dividing, “quiescent” state.
Although the role of this pre-commitment state of cell division is not yet entirely clear, it appears to be a safety mechanism to avoid inappropriate cell division, and may also activate DNA-repair functions. In any case, it appears to be a basic—and until now undiscovered—aspect of cell biology, with likely implications for understanding cancer, wound healing, and other cell division-related processes.

Dr. Tobias Meyer
“We suspect, for example, that some types of cancer cell linger in this intermediate, pre-division state to improve their chances of survival,” said study senior author Dr. Tobias Meyer, the Joseph Hinsey Professor of Cell & Developmental Biology and a professor of biochemistry at Weill Cornell Medicine.
The study’s first author—and co-corresponding author with Dr. Meyer—is Dr. Yumi Konagaya, a postdoctoral researcher in the Meyer Laboratory during the study, now a principal investigator at Riken, a national research institute in Japan.
Cell division is the basic process underlying the growth and development of living things, and even in adult organisms is necessary for the repair of wounds and the general maintenance of tissues. While it has been known that the division process starts in a cell when various input signals trigger the activation of E2F, how this works has always been something of a mystery. The activation process is, in principle, highly sensitive to input signals, yet these signals are very prone to fluctuate—so how does the cell avoid constant, inappropriate E2F activations and cell divisions?
To answer this question, Dr. Konagaya developed the first-ever set of methods for tracking, in individual cells, the detailed activation status of E2F and its signaling partners as the cells move from their usual quiescent state into the division process. With these new tools, she observed that E2F, which is activated by multiple chemical modifications called phosphorylations, often remains in an extended, partial-activation, “primed” state in which some but not all of the necessary phosphorylations have occurred.
“It became clear that cells can stall in this primed state for more than a day before returning to quiescence or advancing to cell division,” Dr. Konagaya said.
It seems likely, according to the researchers, that this intermediate primed state allows cells time to sense and integrate the usual, fluctuating cell division input signals, smoothing this “noise” and reducing the chance of inappropriate division. But the researchers suspect that this state has other functions too, including to facilitate DNA repair, since cells in this state show signs of activated DNA-repair processes. A DNA-repair function could benefit cancer cells as well as healthy cells, Dr. Meyer noted.
“Cancer cells often die when they divide because of the DNA damage they have accumulated, but this intermediate state induces DNA damage-repair machinery, so maybe some cancers use this state to repair themselves before dividing,” he said.
The researchers plan to follow up in part by exploring the role of this intermediate pre-division state in cancers. In principle, having learned the tell-tale phosphorylation pattern of this intermediate state, they could develop tests for identifying cancers in this state, which could help in optimizing treatments.